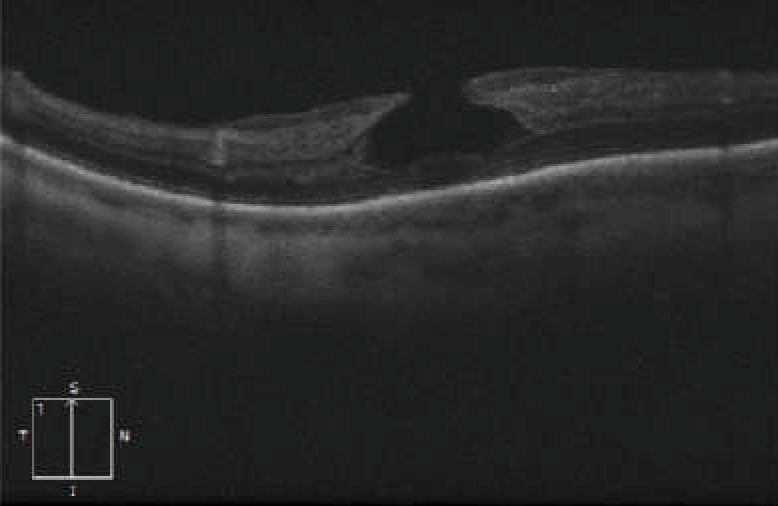
File:LMH.png

File:LMH.png
From EyeWiki
LMH.png (778 × 506 pixels, file size: 115 KB, MIME type: image/png)
Summary
Case of “true” LMH. Can be recognized by its hat-like shape and the presence of epiretinal proliferation above the ganglion cell and nerve fiber layers.
File history
Click on a date/time to view the file as it appeared at that time.
| Date/Time | Thumbnail | Dimensions | User | Comment | |
|---|---|---|---|---|---|
| current | 21:10, January 5, 2024 |  | 778 × 506 (115 KB) | Mélanie.Hébert (talk | contribs) | Case of “true” LMH. Can be recognized by its hat-like shape and the presence of epiretinal proliferation above the ganglion cell and nerve fiber layers. |
You cannot overwrite this file.
File usage
The following page uses this file: